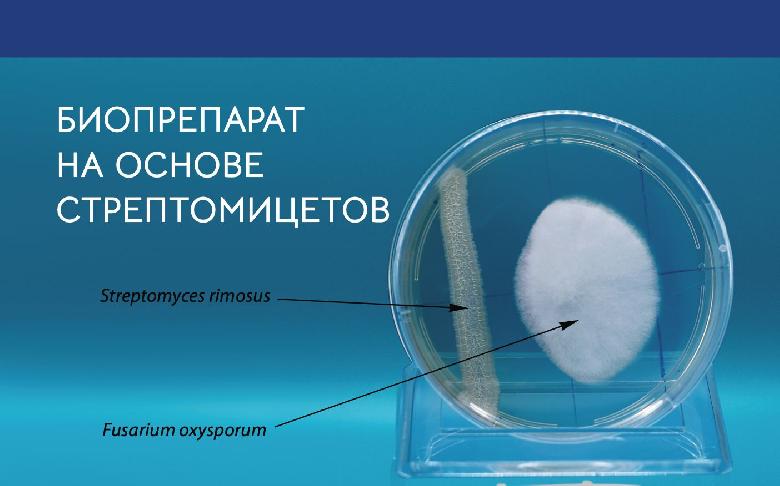
Бактерии рода Streptomyces sp.- основа препарата Веривер

Атлант - инокулянты для бобовых
высококачественные инокулянты для семян зернобобовых культур
Подробнее
Бинал Экстра
Действенная профилактика и эффективная борьба с бактериальными заболеваниями растений
Подробнее
Свидетельства препаратов БИОМ
Группа компаний Биом в 2022 г. получила Свидетельства государственной регистрации на препараты - ТЕТРИС, СП и Планфаг, Ж /СП.
Подробнее